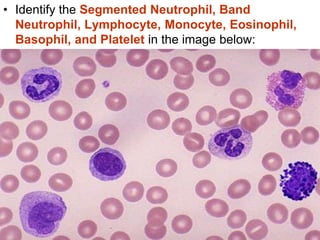
• Identify the Segmented Neutrophil, Band
Neutrophil, Lymphocyte, Monocyte, Eosinophil,
Basophil, and Platelet in the image below:
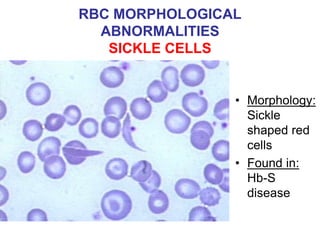
RBC MORPHOLOGICAL
ABNORMALITIES
SICKLE CELLS
• Morphology:
Sickle
shaped red
cells
• Found in:
Hb-S
disease
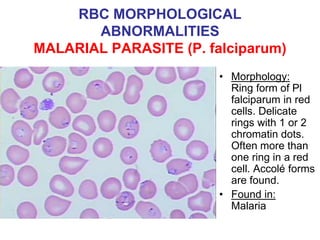
RBC MORPHOLOGICAL
ABNORMALITIES
MALARIAL PARASITE (P. falciparum)
• Morphology:
Ring form of Pl
falciparum in red
cells. Delicate
rings with 1 or 2
chromatin dots.
Often more than
one ring in a red
cell. Accolé forms
are found.
• Found in:
Malaria
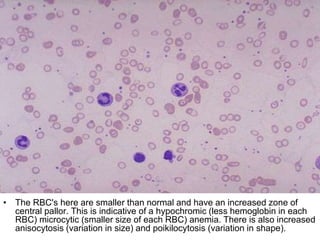
• The RBC's here are smaller than normal and have an increased zone of
central pallor. This is indicative of a hypochromic (less hemoglobin in each
RBC) microcytic (smaller size of each RBC) anemia. There is also increased
anisocytosis (variation in size) and poikilocytosis (variation in shape).
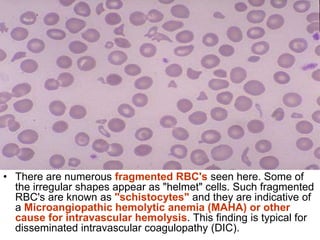
• There are numerous fragmented RBC's seen here. Some of
the irregular shapes appear as "helmet" cells. Such fragmented
RBC's are known as "schistocytes" and they are indicative of
a Microangiopathic hemolytic anemia (MAHA) or other
cause for intravascular hemolysis. This finding is typical for
disseminated intravascular coagulopathy (DIC).
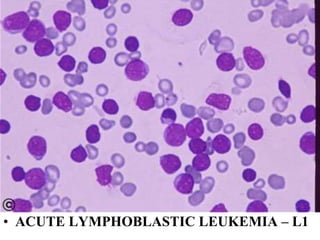
• ACUTE LYMPHOBLASTIC LEUKEMIA – L1
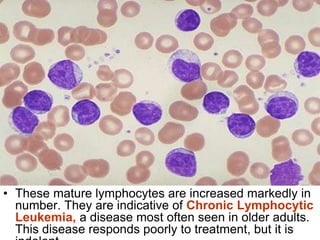
• These mature lymphocytes are increased markedly in
number. They are indicative of Chronic Lymphocytic
Leukemia, a disease most often seen in older adults.
This disease responds poorly to treatment, but it is
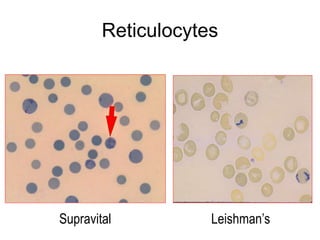
Reticulocytes
Leishman’sSupravital

The document outlines various methods for blood corpuscle counting and the study of formed cellular elements in blood, detailing the composition of blood, types of blood disorders, specimen collection methods, and laboratory tests. It discusses the interpretation of results from tests like CBC, Hb estimation, and differential counts, as well as specific disorders associated with RBC, WBC, and platelet counts. Additionally, it emphasizes the importance of recognizing anemia and its underlying causes, as well as the methodological approaches to diagnosing blood-related conditions.